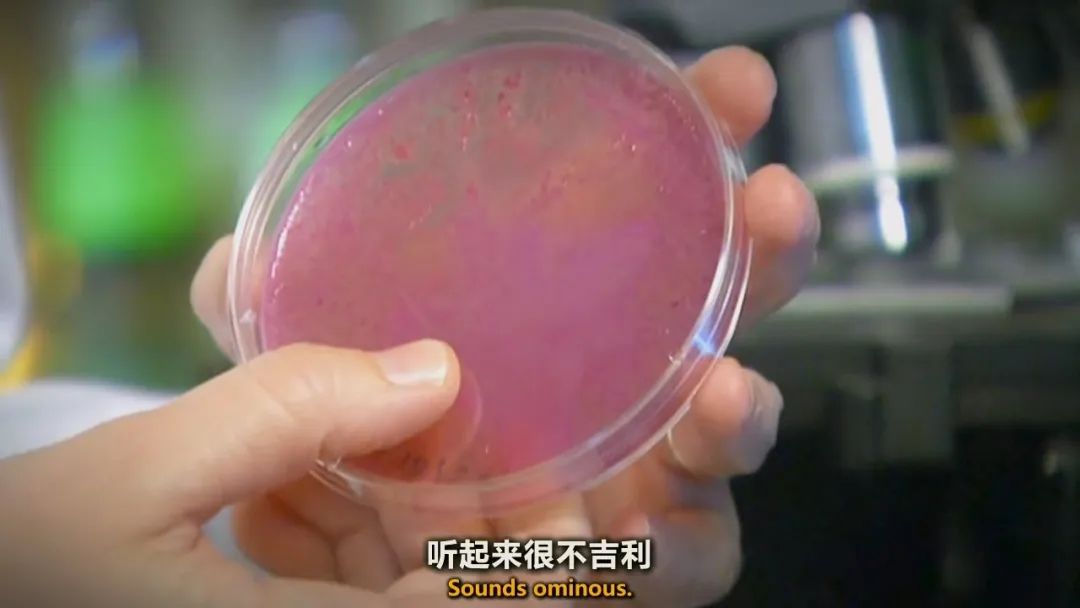

纪录片之家字幕组原创翻译作品
在线观看请点击最下方的“阅读原文”
内容简介

啤酒改变人类的历史进程不只一次,而是从发明后一次又一次地改变,啤酒播种了世界上最早的农田、啤酒打凿了最早的世界奇迹、啤酒建立了现代医疗保健、而且啤酒塑造了美国、甚至终结了史上最大的丑闻之一,这是有史以来最伟大发明的故事,这个惊人的故事却从没人认真讲过!
精彩截图

影片信息
中文名:啤酒拯救世界
字 幕:中英双语特效字幕
在线观看:请点击下方“阅读原文”。
公众号ID:jlpzjsub
专注翻译及分享国外高品质纪录片
新浪微博:纪录片之家字幕组
